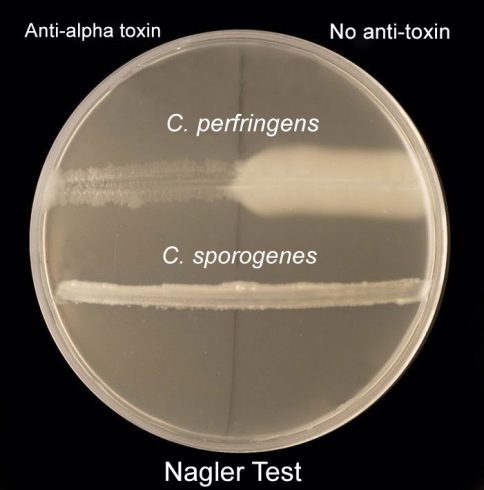
Lecithinase

تکنیک ها
تست لسیتیناز (Lecithinase)
اصول، روش، موارد استفاده و تفسیر
فسفاتیدیلکولین (Phosphatidylcholine) یا به زبان ساده، لسیتین (Lecithin) مادهای است که به طور گسترده در بافتهای حیوانی، زرده تخم مرغ و برخی گیاهان وجود دارد و از فسفولیپیدهای (Phospholipid) متصل به کولین (Choline) تشکیل شده است.
برخی از میکروارگانیسمهای دارای لسیتیناز هستند (که فسفولیپاز C (Phospholipase C) نیز نامیده میشود)، که آنزیمی است که فسفولیپید لسیتین (Phospholipid lecithin) را تجزیه میکند. از این خاصیت لسیتیناز برای تشخیص چندین باکتری گرم مثبت و گرم منفی استفاده میشود.
اهداف
- برای تعیین توانایی میکروارگانیسمها در تولید آنزیم لسیتیناز.
- شناسایی باکتری بر اساس فعالیت لسیتیناز آن.
اصول
Egg Yolk Agar یک محیط کشت افتراقی و غنی شده است که در جداسازی و افتراق احتمالی گونههای مختلف بر اساس فعالیت لسیتیناز آنها استفاده میشود. لسیتین جزء طبیعی زرده تخم مرغ است. در Egg Yolk Agar، جزء لیپوپروتئینی (Lipoprotein) لسیتوویتلین (Lecithovitellin) را میتوان توسط لسیتیناز به فسفوریلکولین (Phosphorylcholine) و یک دی گلیسیرید (Diglyceride) غیر قابل حل تقسیم کرد که منجر به تشکیل رسوب در محیط میشود.
میکروارگانیسمهایی که دارای آنزیم لسیتیناز هستند، لسیتین را به دیگلیسرید و فسفوریلکولین غیر قابل حل تجزیه میکنند و باعث ایجاد یک ناحیه سفید رنگ مات از رسوبات میشوند که فراتر از لبه کلنی پخش میشوند. چنین هاله ماتی که کلنی را در هنگام رشد در محیط Egg Yolk Agar احاطه میکند، نشان دهنده فعالیت لسیتیناز مثبت ارگانیسم مورد آزمایش است.
محیط کشت:
Egg Yolk Agar
ترکیبات:
پانکراس دایجست کازئین (Pancreatic Digest of Casein) 15.0 گرم، ویتامین K1 برابر 10 گرم، کلرید سدیم 5.0 گرم، پاپیک دایجست (Papaic Digest) کنجاله سویا 5.0 گرم، عصاره مخمر 5.0 گرم، L-Cystine 0.4 گرم، Hemin 5.0، محیط کشت Egg Yolk Emulsion 100 میلیلیتر و آگار 20 گرم.
pH نهایی برابر 0.3±7.0 در دمای 25 درجه سانتیگراد.
روش تست
- یک لوپ پر از ارگانیسم آزمایشی را بردارید و آن را به صورت یک خط مستقیم روی پلیت (Plate) به صورت خطی کشت دهید.
- بلافاصله پس از کشت خطی، آن را در جار گاز پک (Gas pak jar) بطور بیهوازی انکوبه کنید و برای ارگانیسمهای بیهوازی به انکوباتور در دمای 35 تا 37 درجه سانتیگراد به مدت 24 تا 48 ساعت منتقل نمایید و برای هوازیها پلیت را در دمای 35 تا 37 درجه سانتیگراد به مدت 24 تا 48 ساعت انکوبه کنید.
- پلیت را از نظر هاله مات اطراف نواحی تلقیح بررسی کنید.
نتایج
نتیجه تست مثبت: ظهور یک ناحیه سفید، مات و پخش شده که درون محیط و در اطراف کلنیها گسترش یافته است.
نتیجه تست منفی: عدم وجود یک ناحیه سفید و مات در امتداد لبه کلنی.
موارد استفاده
- لسیتینازهای باکتریایی به دلیل نقش احتمالی این آنزیمها در بیماریزایی مورد توجه ویژه هستند.
- شناسایی کلستریدیوم پرفرنجنس (Clostridium perfringens)، استافیلوکوکوس اورئوس (Staphylococcus aureus)، سودوموناس آئروژینوزا (Pseudomonas aeruginosa) یا لیستریا مونوسیتوژنز (Listeria monocytogenes)
- از فعالیت لسیتیناز استافیلوکوکوس اورئوس ( aureus) به دلیل پیوند قوی بین فعالیت لسیتیناز و فعالیت کواگولاز (Coagulase) در تشخیص سویههای کواگولاز مثبت استفاده میشود.
- میتوان از این تست برای افتراق بین گونههای خاص در جنس باسیلوس استفاده کرد.
محدودیتها
- توصیه میشود برای شناسایی کامل، آزمایش بیوشیمیایی، ایمونولوژیک (Immunologic)، مولکولی یا طیف سنجی جرمی (Mass spectrometry) روی کلنیهای حاصل از کشت خالص انجام شود.
- حفظ شرایط بیهوازی الزامی است.
- یک آزمایش لسیتیناز منفی باید با یک پلیت کنترل تلقیح نشده مقایسه شود، زیرا لسیتیناز میتواند در کل پلیت آگار منتشر شده و تفسیر را دشوار کند.
مترجم: فاطمه فریادرس





نقش G6PD و لیستین آز در شکنندگی گلبولی چیست
آنزیم G6PD با تولید NADPH از گلبول قرمز در برابر استرس اکسیداتیو محافظت میکند؛ کمبود آن باعث شکنندگی گلبولها میشود.
لیستیناز با تخریب غشای گلبولی باعث افزایش نفوذپذیری و در نهایت همولیز و شکنندگی گلبولها میشود.
آیا لسیتیناز برای تحقیق در دست رس هست؟